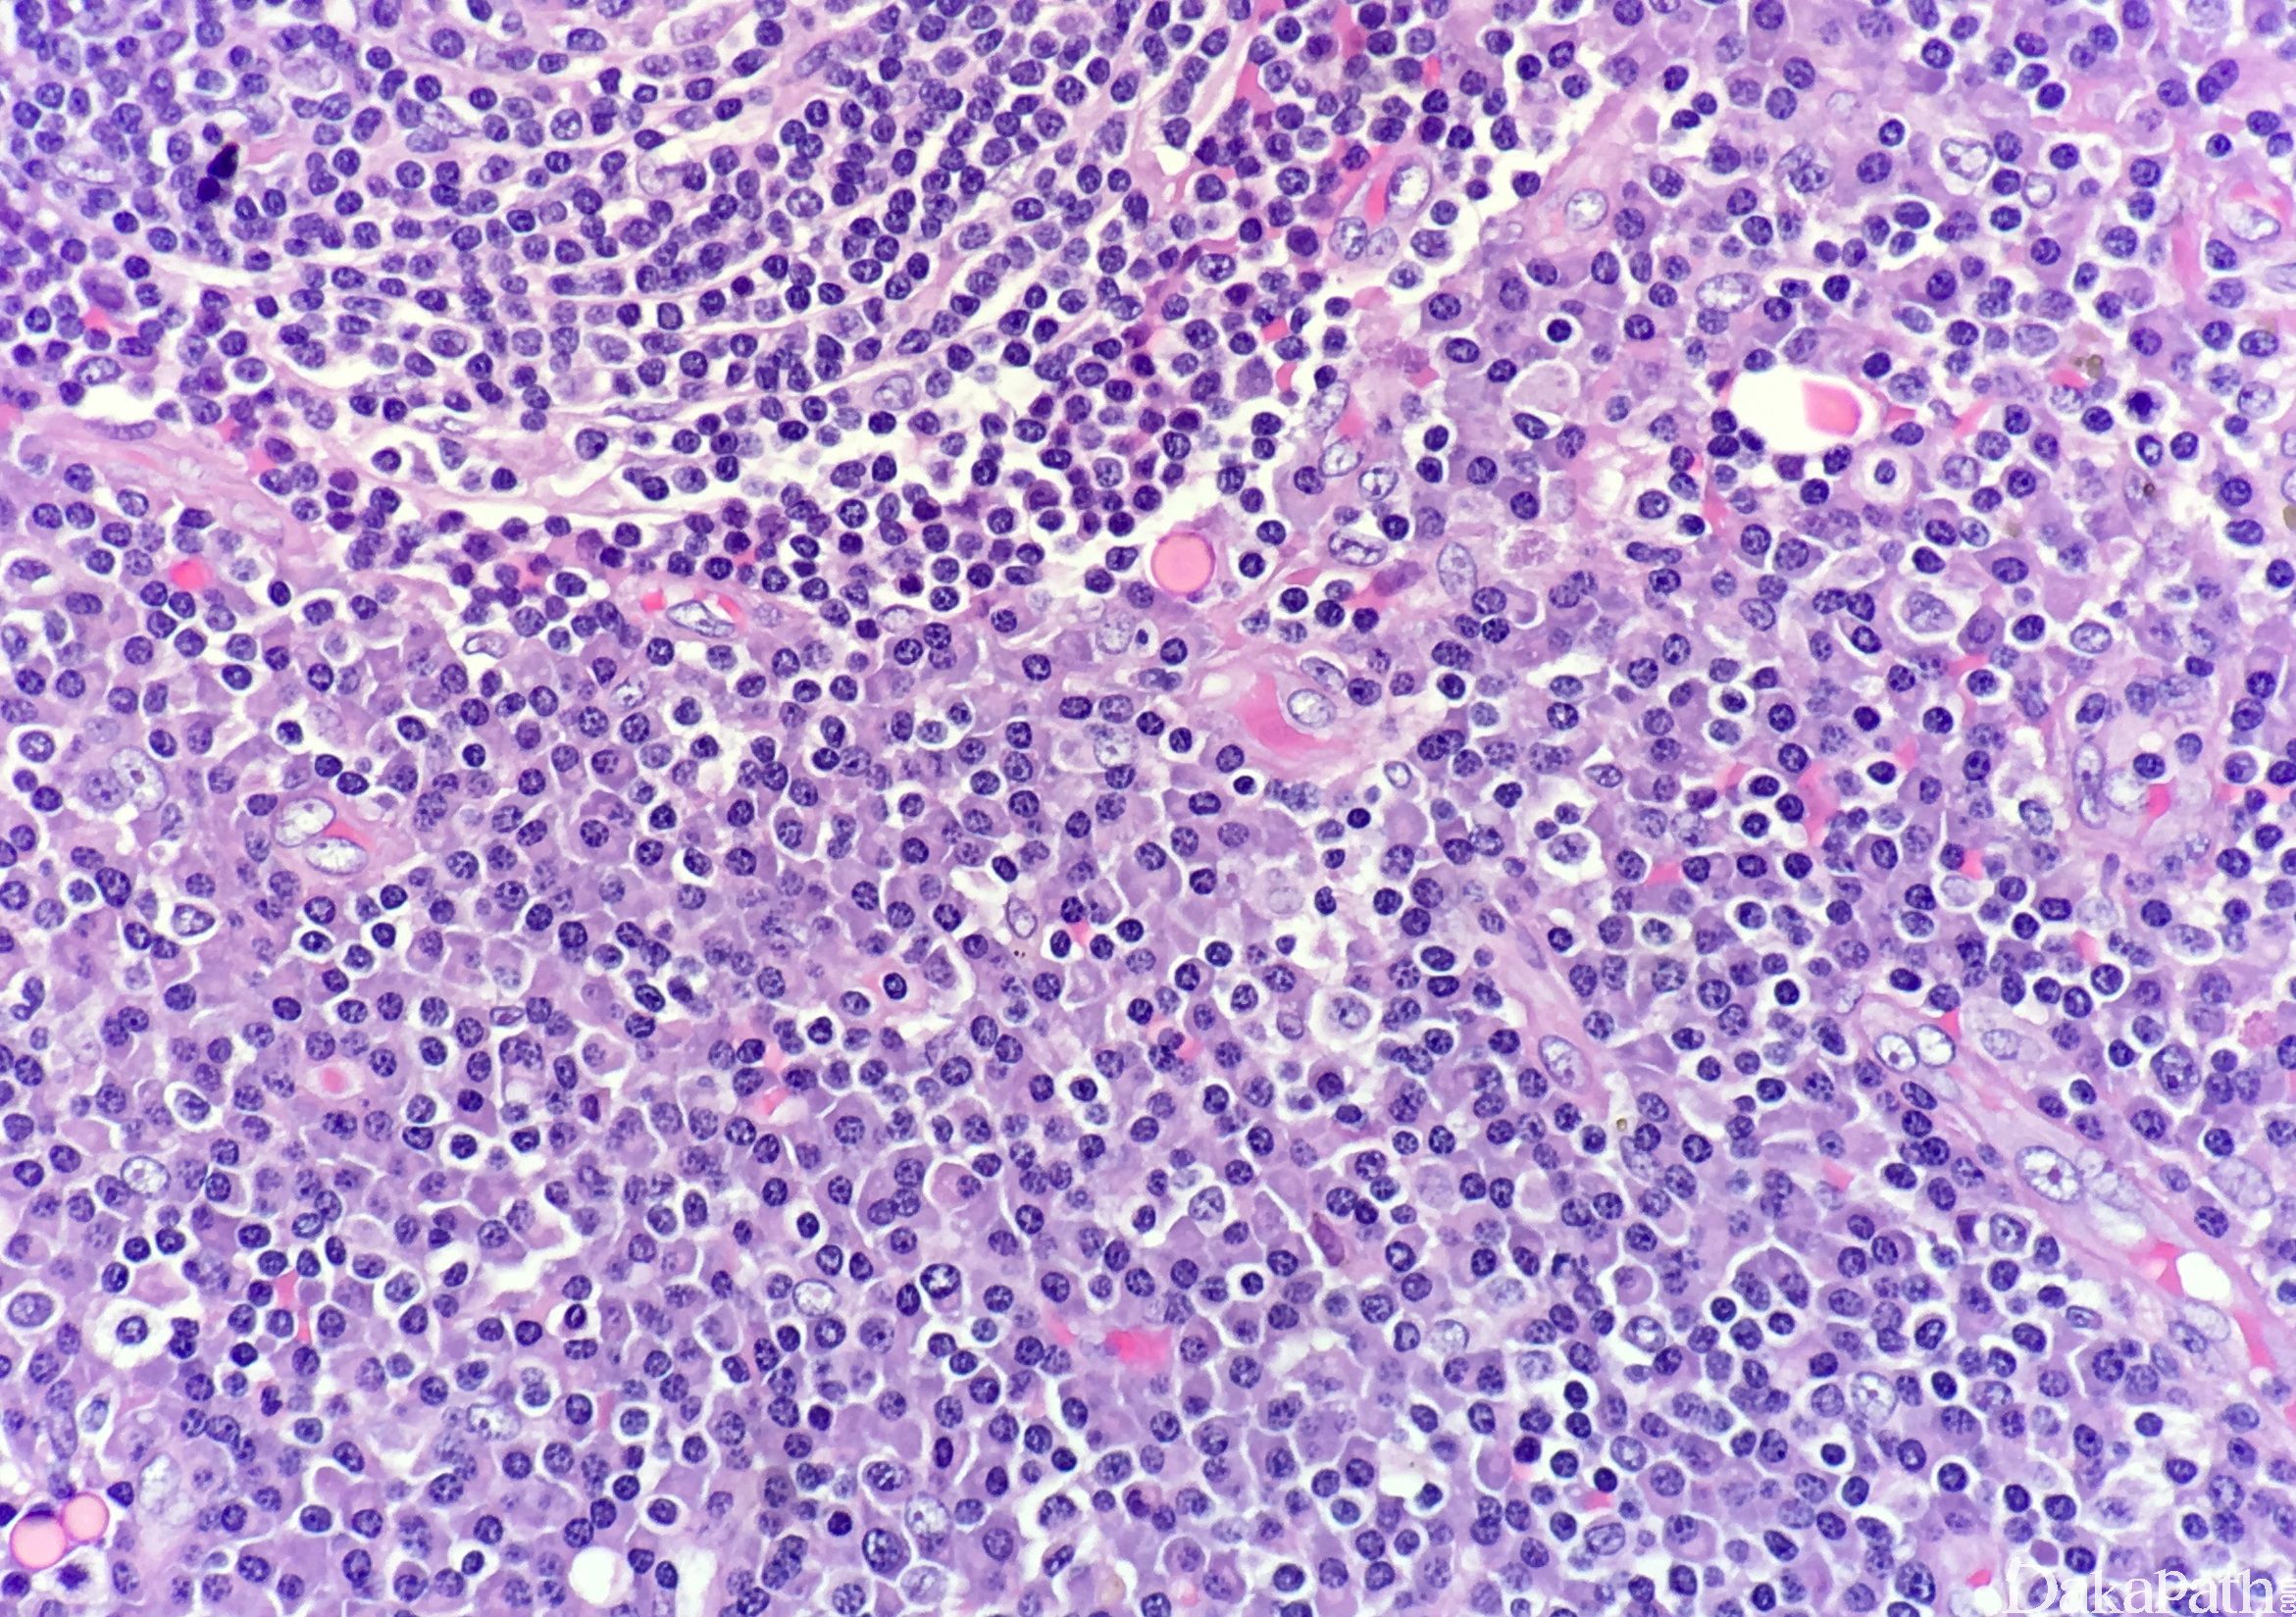

Castleman 病
Castleman Disease
同义词(或曾用名): 巨大淋巴结增生
概述:
Castleman 病(CD)是一种形态上独特的淋巴结增生,而不是一种肿瘤或错构瘤。根据镜下形态分为两种主要类型:玻璃样血管型(透明血管型,HVCD)和浆细胞型(PCCD)。按临床表现也可分孤立型和多中心型(系统型),孤立型 90%以上形态学为玻璃样血管型,常无症状,其余浆细胞型则常伴有发热、贫血、红细胞沉降率增高、高丙种球蛋白短暂症和低蛋白血症。多中心型则几乎为浆细胞型,仅有极少数玻璃样血管型的病例报道,其表现为全身淋巴结肿大,可累及脾,HHV-8 与多中心型 Castleman 病之间有明确的关联。
发病部位: 孤立型(单中心型)最常见于纵隔及颈部淋巴结,也可发生于肺、腋窝、肠系膜、阔韧带、腹膜后、肢体的软组织(皮下、肌骼肌)、鼻咽、脑膜等。 多中心型(系统型):全身淋巴结肿大,也可累及脾脏。
诊断要点:
可发生于任何年龄,青年人多见;最常累及纵隔和颈部淋巴结,为圆形、境界清楚、切面呈灰白色的实性肿块,直径可达 15cm 以上。
临床表现:透明血管型(HVCD)常为局限性肿块,一般没有 HIV 感染,无系统性症状,常呈自限性,发展为滤泡树突状细胞肉瘤的风险很小。浆细胞型(PCCD)常引起全身炎症和淋巴结肿大,伴有发热、贫血、红细胞沉降率增高、高丙种球蛋白短暂症和低蛋白血症,可能发展为淋巴瘤,并可能与 HHV-8 和 HIV 相关。
组织学形态:镜下见增生的淋巴组织中散在分布的大淋巴滤泡,滤泡间血管增多,可见滤泡间的血管垂直插入生发中心形成“棒棒糖”样生发中心。套区膨胀形成向心性环状结构,与滤泡树突细胞相连,呈“洋葱皮”样,一个套区可包绕 2 个或多个生发中心;生发中心萎缩,主要细胞为滤泡树突细胞和增生的血管内皮细胞。组织学上根据血管、生发中心的透明变性和浆细胞增生情况分为透明血管型(HVCD)和浆细胞型(PCCD)。
透明血管型(HVCD)表现增生的大滤泡中显著的血管增生和异常的生发中心玻璃样变性。
浆细胞型(PCCD)表现为滤泡间有弥漫的浆细胞增生,可伴有较多的 Russell 小体,滤泡间的玻璃样血管改变可不明显或没有,滤泡中心常可见无定型的嗜酸性物质沉积。
免疫组织化学染色:
滤泡树突网表达 CD21。CD123. CD68. CD43 标记浆细胞样树突细胞;HHV-8 在 HVCD 中常阴性;PCCD 型浆细胞常为轻链多克隆,但多中心型 PCCD 可以检出轻链限制性浆细胞 (常为 Lambda)。
鉴别诊断:
晚期 HIV 相关淋巴结病:临床病史和血清学检查可以排除 HIV 感染相关淋巴结病。
反应性滤泡增生:Castleman 病的生发中心是萎缩的,而反应性滤泡的生发中心一般增大,有极向、吞噬小体,一个滤泡没有 2 个或多个生发中心、血管垂直插入、套区“洋葱皮”样外观等特征,没有透明变或明显浆细胞增生。
类风湿关节炎相关淋巴结病(RAL):虽然两者都表现为明显的滤泡增生和滤泡间浆细胞增多,并可有透明嗜酸性物质沉积,但 RAL 没有 CD 常见的一个滤泡可有 2 个或多个生发中心、血管垂直插入、套区“洋葱皮”样外观等特征,结合病史和血清 RF 因子阳性可鉴别两者。
血管免疫母细胞性 T 细胞淋巴瘤(AITL);在 AITL 的早期,肿瘤性异型细胞主要在滤泡间区漫润,高内皮静脉与 HVCD 中增生的血管类似,但 AITL 中异型的肿瘤细胞胞质透亮、表达 CD10 和 PD-1;AITL 中 CD21 显示扩张的虑泡网位于 B 细胞滤泡外(需注意的是 AITL 中可含有萎缩的生发中心);另外,早期 AITL 中滤泡间区浸润的免疫母细胞 EBER 阳性。
套细胞林巴瘤:套细胞淋巴瘤中的林巴细胞常有异型性、轻链限制性,表达 CD5 及 CyclinD1,无滤泡间区血管增生的特征。
滤泡性淋巴瘤:滤泡性淋巴瘤生发中心密集,滤泡间区减小,没有明显的套区增生,并有典型的免疫表型和分子特征,CD20 +、CD10 +、Bcl2 +和 t(14;18)。
浆细胞瘤:浆细胞瘤可与 CD 的浆细胞变异型混淆。但浆细胞瘤没有 CD 的一个滤泡 2 个或多个生发中心、血管垂直插入、套区“洋葱皮”样外观等特征,没有透明血管滤泡、滤泡间血管增生、HHV8+等。
结节硬化型经典型霍奇金淋巴瘤(NSHL):两者都常发生于纵隔,NSHL 典型的 RS 细胞和异型大细胞、特征性免疫组化(CD30+、CD15+、PAX5+、MUM1+)可鉴别。
治疗:
孤立性 Castleman 病手术切除可治愈;多中心性 Castleman 病需要系统性化疗。